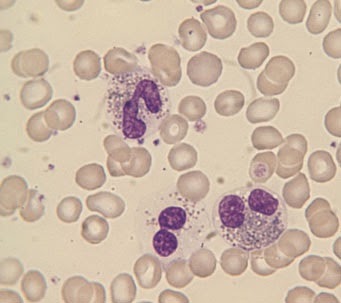

White cells and platelets may be increased or decreased in number. They may also show morphological abnormalities, either inherited or acquired. Assessing whether the numbers of individual types of white cell are increased or decreased requires a differential count. However, the differential count is of little importance in itself and should only be used to calculate the absolute numbers of each cell type. The absolute counts are then compared with those expected in healthy people of the same age, sex and ethnic group. The terms used in describing numerical abnormalities in white cells and platelets are defined in Table 3.1.
![]() |
| Table 3.1 Terminology used for abnormalities of white cell and platelet numbers |
Assessing white cell and platelet numbers
White blood cell counts can be assessed by examining a blood film, preferably by low power, but an instrumental WBC is much more precise. Figure 3.1 illustrates leucocytosis. In com- parison, if the WBC were normal, no more than one or two cells would be expected in a microscopic field of this size and if there were leucopenia many such fields would contain no white cells.
Platelet numbers can also be assessed on a film, by relating their number to the number of red cells present. An instrument platelet count is generally much more precise than an estimate from a film but is prone to errors because of poor specimen collection techniques or characteristics of the sample. If a plate- let count is unexpectedly low it is important to check that this is not because the specimen is partially clotted. Some automated instruments have a mechanism for checking for clots but other- wise this has to be done manually by the laboratory worker. It is important that all low platelet counts are confirmed on a blood film. Figures 3.1, 3.2 and 3.3 contrast normal, high and low platelet counts. It is also important to examine a blood film in all cases with apparent thrombocytopenia to exclude platelet aggre- gation or satellitism (see Figs 1.21 & 1.23) as a cause of a falsely low count.
Assessing neutrophil morphology
Neutrophils may show increased (Fig. 3.4) or decreased (see Fig. 1.13) granulation. Increased granulation is usually a reaction to infection or inflammation and is therefore referred to as toxic granulation. However, it does also occur as a normal phenom- enon, during pregnancy. Cytoplasmic inclusions may be present as an inherited or acquired abnormality. The commonest such abnormality is a small, pale, blue–grey inclusion which occurs both during pregnancy and in infection and inflammation and is known as a Döhle body (Fig. 3.5). Another common cytoplasmic abnormality, which is strongly suggestive of infection, is cyto- plasmic vacuolation (Fig. 3.4).
![]() |
Fig. 3.1 Leucocytosis.
|
![]() |
Fig. 3.2 Thrombocytopenia (in Wiskott–Aldrich syndrome). There are only two
platelets in the film. The platelets are also abnormally small,
although
their staining characteristics are normal. |
![]() |
Fig. 3.3 Thrombocytosis (in chronic granulocytic leukaemia). The platelets
also show increased
variation in size and some are agranular.
|
Neutrophils may have congenital or acquired abnormalities of nuclear lobulation. An increase in band forms and less lobulated neutrophils in relation to more mature, well-lobulated neu- trophils is known as a left shift (Fig. 3.4). This term is also used when neutrophil precursors are present in the blood. Neutrophils
![]() |
| Fig. 3.4 Toxic granulation, vacuolation and left shift (the two white cells are band forms). |
![]() |
| Fig. 3.5 A neutrophil containing a Döhle body, a small blue–grey cytoplasmic inclusion which can be seen just below the nucleus. |
may also be hypolobulated, but with very round lobes and with some nuclei being shaped like a pair of spectacles or a peanut. This occurs as a congenital abnormality known as the Pelger– Huët anomaly (Fig. 3.6). There will be some neutrophils with completely round nuclei. This congenital anomaly is of no clin- ical significance but it is important not to confuse it with left shift. A similar abnormality can develop as an acquired condi- tion known as the pseudo- or acquired Pelger–Huët anomaly. The acquired Pelger–Huët anomaly is clinically very significant because it is a feature of a neoplastic condition, called a myelo- dysplastic syndrome, which may lead on to acute leukaemia. The nuclei have similar abnormal shapes in the congenital and acquired Pelger–Huët anomalies but in the latter there are often associated abnormalities (e.g. neutropenia or hypogranular neutrophils). Neutrophils may also show increased lobulation (Fig. 3.7). This is known as right shift. Neutrophils with six or more lobes are said to be hypersegmented. Neutrophil hyperseg- mentation is an important clue to the presence of deficiency of vitamin B12 or folic acid. Macropolycytes (Fig. 3.8) should not be confused with hypersegmented neutrophils: they are twice the size of normal neutrophils and the nucleus is twice as big. This is because one cell division has been missed during neutrophil production. Macropolycytes are likely to have 92
![]() |
| Fig. 3.6 A neutrophil with two very round lobes in a patient with the congenital Pelger–Huët anomaly. |
![]() |
| Fig. 3.7 A hypersegmented neutrophil in a patient with megaloblastic anaemia. The neutrophil nucleus has seven lobes. |
rather than 46 chromosomes, i.e. they are likely to be tetraploid rather than diploid. Although their nuclei may have six or more lobes, macropolycytes do not have the same significance as hypersegmented neutrophils and should be distinguished from them.
Granulocyte precursors and nucleated red cells may be present simultaneously in the peripheral blood. This can occur as a normal phenomenon in pregnancy but otherwise it is mainly seen in severely ill patients, who are usually anaemic. The anae- mia is referred to as a leucoerythroblastic anaemia. Leucoeryth- roblastic anaemia is indicative of either a bone marrow disease (e.g. idiopathic myelofibrosis), bone marrow infiltration (e.g. by carcinoma cells) or a severe systemic illness (e.g. severe infection or haemorrhagic shock).
Assessing lymphocyte morphology
Congenital abnormalities of lymphocytes are rare. Most abnor- malities of lymphocyte morphology are caused by viral infec- tions. Less often, increased numbers of lymphocytes showing a variable degree of morphological abnormality are indicative of a neoplastic process, either a lymphoid leukaemia or a lymphoma (see Chapter 4). The most striking reactive changes in lympho- cyte morphology are seen in infectious mononucleosis, an illness caused by an acute infection by the Epstein–Barr (EB) virus. There is lymphocytosis and lymphocytes are morphologically very abnormal (Fig. 3.9). Some are very large, some have primi- tive nuclei with a diffuse chromatin pattern and nucleoli, some nuclei are lobulated, some cells have voluminous basophilic cytoplasm. The cells are pleomorphic, i.e. they vary greatly in size and shape. The lymphocytes are so abnormal that initially their true nature was not known and they were referred to as atypical mononuclear cells. Now they are more often referred to as atypical lymphocytes. Large numbers of atypical lym- phocytes, similar to those seen in infectious mononucleosis, can also occur in infection by cytomegalovirus, hepatitis A virus and adenovirus and during the parasitic infection, toxoplasmosis. Smaller numbers of atypical lymphocytes are seen in many other viral, bacterial, rickettsial and protozoan infections.
Other reactive changes, in addition to those typical of infectious mononucleosis, occur in lymphocytes both during infection and during exposure to other antigenic stimuli. B lymphocytes may differentiate into plasma cells (Fig. 3.10) with an increased amount of basophilic cytoplasm, a pale-staining
![]() |
| Fig. 3.9 Atypical lymphocytes (in infectious mononucleosis). |
![]() |
| Fig. 3.10 A plasma cell (occurring as a reactive change in a patient with infection). The chromatin is clumped and a Golgi zone is apparent below the nucleus. |
area near the nucleus (the Golgi zone) and an eccentric nucleus with clumped chromatin. There may also be plasmacytoid lym- phocytes with characteristics intermediate between those of lymphocytes and plasma cells. An increase of large granular lymphocytes can also occur as a reactive change, e.g. during chronic viral infection. These cells may be indistinguishable from normal large granular lymphocytes but sometimes they show features of activation such as a larger size and more volu- minous basophilic cytoplasm.
Characteristic morphological changes occur in lymphocytes in different types of leukaemia and lymphoma (see Chapter 4).
Assessing morphology of monocytes, eosinophils and basophils
Numerical changes in monocytes, eosinophils and basophils are often useful in diagnosis but this is less often the case with morphological changes. Monocytes can show increased size and cytoplasmic vacuola- tion during infection. Immature monocytes with increased gran-
![]() |
| Fig. 3.11 Eosinophil leucocytosis with one of the three eosinophils being markedly hypogranular. |
ulation and cytoplasmic basophilia can occur both in infections and in leukaemia and related conditions.
Eosinophils can show a variety of morphological abnormalities (Fig. 3.11) including hyper- and hypolobulation, reduced granula- tion and cytoplasmic vacuolation. However, these changes occur in reactive eosinophilia (e.g. in parasitic infection) and also in eosinophilic leukaemia so they are not useful in differential diagnosis.
Basophils sometimes show reduced granulation but since this can occur as a laboratory artefact as well as during allergic reac- tions and in leukaemia and related disorders, its detection is not very helpful in diagnosis.
Assessing platelet morphology
Platelets may be smaller than normal (Fig. 3.2) or, more often, larger than normal (Fig. 3.3). Very large platelets are sometimes referred to as giant platelets. An increased variability in platelet size is referred to as platelet anisocytosis (Fig. 3.3). Platelet size is of diagnostic significance, particularly if considered in relation to the platelet count. Small or normal-size platelets in associa- tion with thrombocytopenia suggest that the cause is a failure of bone marrow production, whereas thrombocytopenia with large platelets is more likely to be caused by peripheral destruction or consumption of platelets with the bone marrow responding by increasing platelet production. Platelet size is also useful in assessing the likely cause of thrombocytosis. In reactive throm- bocytosis (e.g. caused by severe infection or inflammation) the platelets are usually of normal size, whereas when thrombocyto- sis is a feature of a myeloproliferative disorder (chronic granulo- cytic leukaemia, essential thrombocythaemia or polycythaemia rubra vera) platelet size is generally increased and some giant platelets are present. Platelets may show defective or absent granulation. Often this is an artefactual change, because the blood specimen has partly clotted or because platelets have aggregated and have discharged some or all of their granules (see Fig. 1.21). If an artefact is excluded then the detection of defectively granulated platelets is of diagnostic significance. It occurs as a rare congenital anomaly (the grey platelet syndrome), but usually it is consequent on a bone marrow disease such as one of the myeloproliferative or myelodysplastic disorders.

I''m Charlotte Johnson,65 years old, Here in Edmonton, Canada. With the new herbal mix medicine I purchased from Dr James herbal mix medicine West Africa was my only way to get rid of my Alzheimer's, the herbal mix medicine effectively reversed my condition and alleviate all symptoms. I was initially very hesitant to discuss my Alzheimer but I just hope it can still help someone. I feel this will be very important information for all Alzheimer patients, because the most violent element in society today is ignorance. Be it any condition, a healthy diet and natural herbs and roots medicine from Dr. James is the road to fast recovery. I had suffered Alzheimer for many years, I fought for proper medical recommendation, care and all form of humane treatment with little improvement I went through many sleepless nights and periods of intense grief, as do most families. I was recommended by a friend to use Dr. James herbal mix medicine for my Alzheimer with high hope and assurance. I never doubted my friend but to contact Dr. James. And purchased His herbal mix medicine which was effective and I finally feel my Alzheimer is gone with no more symptoms. He also told me that he cures diseases such as Lungs diseases, kidney diseases, Warts, Bipolar disorder, Shingles, HPV, ALS, CANCER, NEPHROTIC SYNDROME, HIV / AIDS, Herpes virus, Ovarian Cancer, Pancreatic cancers, bladder cancer, prostate cancer, Glaucoma., Cataracts, Macular degeneration, Cardiovascular disease, Autism. Enlarged prostate, Osteoporosis. Alzheimer's disease, psoriasis, Tach Diseases, Lupus, Backache, dementia, skin cancer,.testicular Cancer, Leukemia, HEPATITIS A, B, C, Contact the great one on his email greatcureman@gmail.com
ReplyDeleteInfo @ drjamesherbalmix@gmail.com
I saw so many testimonies about Dr Itua a great HERBAL DOCTOR that can cure all kind of diseases and give you the rightful health to live a joyful life, I didn't believe it at first, but as the pain got worse and my life was at risk after visiting my therapist numerous times for combination of treatments. And no changes so I decided to take a try, I contacted him also and told him I want a cure for Vulvar cancer/ Testicular cancer and it was Stage IIIA, he gave me advice on what I must do and he delivered it to me in my state which I use according to his instruction, and today I must say I am so grateful to this man Dr Itua for curing me from Vulvar cancer/ Testicular cancer and for restoring me back to my normal health and a sound life, I am making this known to every one out there who have been living with cancers all his life or any sick person should not waste more time just contact him with his details below- WhatsApp- +2348149277967 Email drituaherbalcenter@gmail.com, believe me this man is a good man with Godly heart, this is the real secret we all have been searching for. Do not waste more time contacting him today for you to also live a sound and happy life. He cures the following disease, thyroid Cancer, Uterine cancer, Fibroid, Arthritis, Brain Tumor,Fibromyalgia, Bladder cancer, Brain cancer, HIV, Herpes, Esophageal cancer, Gallbladder cancer, Gestational trophoblastic disease, Head and neck cancer, Hodgkin lymphoma Intestinal cancer, Kidney cancer,Hpv, Lung cancer, Melanoma,Mesothelioma, Multiple myeloma,Neuroendocrine tumors Non-Hodgkin lymphoma, Oral cancer, Ovarian cancer, Sinus cancer, Hepatitis A, B/C, Skin cancer, Soft tissue sarcoma, Stroke, Lupus, Spinal cancer, Stomach cancer, Vaginal cancer,Vulvar cancer, Testicular cancer,Tach Diseases, Pancreatic Cancer, Leukemia, Liver cancer, Throat cancer, Alzheimer's disease, Chronic Diarrhea,Copd, Parkinson,Als,Adrenocortical carcinoma Infectious mononucleosis.
ReplyDeleteThank You and I have a dandy proposal: How Long Renovate House house repair quotation
ReplyDelete